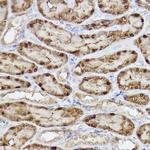
ABH1 Antibody in Immunohistochemistry (Paraffin) (IHC (P))

Search
Invitrogen
ABH1 Recombinant Rabbit Monoclonal Antibody (5K4W5)
{{$productOrderCtrl.translations['antibody.pdp.commerceCard.promotion.promotions']}}
{{$productOrderCtrl.translations['antibody.pdp.commerceCard.promotion.viewpromo']}}
{{$productOrderCtrl.translations['antibody.pdp.commerceCard.promotion.promocode']}}: {{promo.promoCode}} {{promo.promoTitle}} {{promo.promoDescription}}. {{$productOrderCtrl.translations['antibody.pdp.commerceCard.promotion.learnmore']}}
图: 1 / 3
ABH1 Antibody (MA5-35781) in IHC (P)

Please note: We are reviewing Western blot images included in the antibody testing data in our catalog, including those provided by third parties. Unless expressly labeled or annotated as “raw-unedited”, Western blot images included in the antibody testing data in our catalog may have been edited, optimized or otherwise adjusted for presentation.
产品信息
MA5-35781
种属反应
宿主/亚型
Expression System
分类
类型
克隆号
抗原
偶联物
形式
浓度
规格
纯化类型
保存液
内含物
保存条件
运输条件
RRID
产品详细信息
Immunogen sequence: MGKMAAAVGS VATLATEPGE DAFRKLFRFY RQSRPGTADL EGVIDFSAAH AARGKGPGAQ KVIKSQLNVS SVSEQNAYRA GLQPVSKWQA YGLKGYPGFI
靶标信息
This gene encodes a homolog to the E. coli alkB gene product. The E. coli alkB protein is part of the adaptive response mechanism of DNA alkylation damage repair. It is involved in damage reversal by oxidative demethylation of 1-methyladenine and 3-methylcytosine. Dioxygenase that repairs alkylated single-stranded DNA and RNA containing 3-methylcytosine by oxidative demethylation. Requires molecular oxygen, alpha-ketoglutarate and iron. May have a role in placental trophoblast lineage differentiation. Has DNA lyase activity and introduces double-stranded breaks at abasic sites. Cleaves both single-stranded DNA and double-stranded DNA at abasic sites, with the greatest activity towards double-stranded DNA with two abasic sites.
仅用于科研。不用于诊断过程。未经明确授权不得转售。
篇参考文献 (0)
生物信息学
蛋白别名: Alkylated DNA repair protein alkB homolog 1; Alpha-ketoglutarate-dependent dioxygenase ABH1; DNA 6mA demethylase; DNA lyase ABH1; DNA N6-methyl adenine demethylase ALKBH1; DNA oxidative demethylase ALKBH1; mRNA N(3)-methylcytidine demethylase; Nucleic acid dioxygenase ALKBH1; tRNA N1-methyl adenine demethylase
基因别名: 2700073G19Rik; ABH; ABH1; alkB; ALKBH; ALKBH1; hABH
UniProt ID: (Mouse) P0CB42
Entrez Gene ID: (Rat) 362766, (Mouse) 211064




